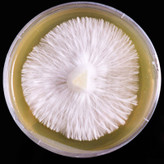
عکس پلیت قارچ گانودرما

نژاد قارچ ترکی تیل یا دم بوقلمون روی پلیت آگار
🧬 نژادها و ژنتیک قارچ ترکی تیل (Trametes versicolor)
قارچ ترکی تیل (Turkey Tail) با نام علمی Trametes versicolor یکی از شناختهشدهترین قارچهای دارویی جهان است که به دلیل داشتن ترکیبات ایمنیافزا و ضدتومور مورد توجه گستردهی پژوهشگران و صنایع دارویی قرار گرفته است.
ترکی تیل دارای دو ترکیب فعال اصلی به نامهای PSK (Polysaccharide-K) و PSP (Polysaccharide-Peptide) است که در تحقیقات بالینی، اثرات مثبتی در تقویت سیستم ایمنی، کاهش عوارض شیمیدرمانی، بهبود عملکرد کبد و افزایش مقاومت بدن در برابر بیماریها نشان دادهاند.
در مجموعه قارچشناسان (Dr. Mushroom) نژادهای مختلف قارچ ترکی تیل با منشأ ژنتیکی معتبر و خلوص آزمایشگاهی بالا نگهداری و تکثیر میشوند. هر نژاد بر اساس بازده رشد، میزان تولید پلیساکارید، تراکم میسیلیوم و رنگ بافت قارچ انتخاب شده و برای عصارهگیری، کشت مایع و مصارف دارویی و پژوهشی مناسب است.
🌿 ویژگی نژادهای Turkey Tail در مجموعه Dr. Mushroom:
-
خلوص ژنتیکی بالا و بدون آلودگی قارچی یا باکتریایی
-
توانایی بالا در تولید پلیساکاریدهای فعال (PSK و PSP)
-
رشد سریع روی محیطهای لیگنوسلولزی (چوب، خاکاره، سبوس)
-
پایداری ژنتیکی در کشتهای مکرر
-
مناسب برای کشت صنعتی، استخراج عصاره و تحقیقات دارویی
🌱 روش کشت خلاصهشده قارچ ترکی تیل
بستر رشد: خاکاره چوب پهنبرگ + سبوس گندم + سبوس برنج + کلسیم کربنات
استریل: ۱۲۱°C به مدت ۲ ساعت
تلقیح: با اسپان خالص ترکی تیل
رشد میسیلیوم (Colonization):
-
دما: ۲۴–۲۶°C
-
رطوبت: ۶۵–۷۰٪
-
مدت رشد: ۲۰–۲۵ روز در تاریکی کامل
میوهدهی:
-
دما: ۲۰–۲۲°C
-
رطوبت: ۸۵–۹۰٪
-
نور سفید ملایم (۶–۸ ساعت در روز)
-
تهویه مناسب برای تشکیل کلاهکهای چندلایه و رنگدار
-
برداشت: ۴۵–۵۵ روز پس از تلقیح
⚙️ نکات کلیدی کشت
-
استفاده از چوبهای تازه و بدون کپک برای رشد یکنواخت ضروری است
-
نور مناسب برای تشکیل حلقههای رنگی مشخص در سطح قارچ اهمیت دارد
-
قارچ خشکشده باید در دمای پایین (زیر ۴۰°C) خشک شود تا ترکیبات فعال حفظ شوند
📦 خدمات Dr. Mushroom:
-
فروش نژادهای خالص ترکی تیل (پلیت، اسپان، لیکویید کالچر)
-
عرضه سویههای تخصصی با تولید بالای PSK و PSP
📍 سفارش و مشاوره:
🌐 www.gharchshenasan.ir
📲 واتساپ: 09357269696
📩 اینستاگرام: @dr.mushroommm